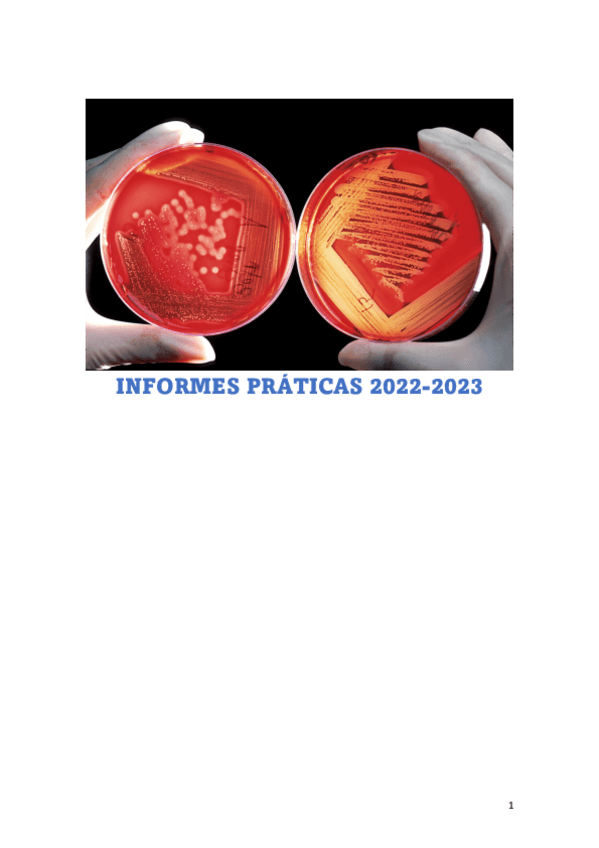

@cotufito
37 Publicaciones
962 Interacciones
3 Seguidores
2 Siguiendo
Lista de publicaciones de cotufito
He publicado nuevos apuntes de 4º Patología Quirúrgica: Trauma-completo.pdf
He publicado nuevos apuntes de 4º Reproducción y Obstetricia: Ciclos-hembras-ingles.pdf
He publicado nuevos apuntes de 1º Anatomía Sistemática: Tema-24-visceras.pdf
apuntes
-
Apuntes micro
He publicado nuevos apuntes de 2º Microbiología e Inmunología: Apuntes micro
He publicado nuevos apuntes de 3º Diagnóstico Por la Imagen: Diferentes-patrones-a-pulmonares.pdf
He publicado nuevos practicas de 2º Microbiología e Inmunología: informes-practicas-micro-22-23.pdf
He publicado nuevos apuntes de 1º Anatomía Sistemática: Articulaciones-la-columna-y-torax-con-dibujos-explicativos.pdf
He publicado nuevos apuntes de 1º Anatomía Sistemática: Anatomia-huesos-dibujos-explicatorios.pdf
He publicado nuevos apuntes de 4º Higiene Alimentaria: Preguntas-desarrollo-bilingue-enero-2023.pdf
He publicado nuevos apuntes de 4º Higiene Alimentaria: test-higiene-resuelto-bilingue.pdf
apuntes
-
Fotos prácticas explicadas
He publicado nuevos apuntes de 2º Parasitología: Fotos prácticas explicadas
apuntes
-
Apuntes agricultura
He publicado nuevos apuntes de 1º Agricultura: Apuntes agricultura
He publicado nuevos apuntes de 1º Etnología, Etología y Bienestar Animal: Regiones-equinas.pdf
He publicado nuevos apuntes de 1º Citología e Histología: cuaderno-practicas-cito-nota-10.pdf